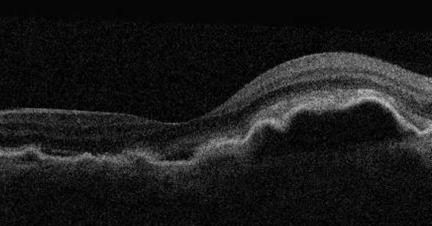
Nestekertymää silmänpohjan verkkokalvokerrosten alla

Näkeminen on ihmisen tärkein aisti
Arviolta jopa 80 % kaikista ihmisen aistihavainnoista perustuu näköaistiin. Näöstä kannattaa siis pitää hyvää huolta. Näkeminen koostuu monesta osa-alueesta. Keskeinen tarkan näkemisen alue auttaa meitä näkemään tarkasti yksityiskohdat. Se auttaa meitä mm. lukemisessa, käsitöissä, kirjoittamisessa sekä toisten ihmisten ilmeiden ja eleiden tulkinnassa. Ääreisnäkeminen puolestaan täydentää tarkan näkemisen aistihavaintoja. Se auttaa meitä havaitsemaan liikettä sekä valon muutoksia.
Silmän etuosassa sijaitseva valoa läpäisevä sarveiskalvo on yksi kriittisimpiä alueita näkemisen kannalta. Vaikka sarveiskalvo on keskimäärin vain noin 0,55 mm paksu, sen osuus silmän kokonaistaittovoimasta on noin 75 %. Tästä syystä sitä kannattaa suojella tulehduksilta sekä ulkoisilta iskuilta esimerkiksi CE-hyväksytyillä silmäsuojaimilla, joita saa myös omilla voimakkuuksilla. Myös sarveiskalvon kuivuminen heikentää merkittävästi näkemistä ja silmien hyvinvointia.
Silmän takaosassa sijaitseva tarkan näkemisen alue, makula, on toinen kriittinen osa näköjärjestelmäämme. Makulan hyvinvointia voi usein parantaa terveillä elämäntavoilla, ruokavaliolla, luteelipitoisilla lisäravinteilla sekä suojautumalla haitallisilta säteilyiltä, kuten infrapuna- sekä UV-säteilyiltä esimerkiksi laadukkaita aurinkolaseja käyttäen. Myös pilvisellä ilmalla ulkona on yllättävän paljon UV-säteilyä.

Optometristi Olli Lappalainen tutkii silmäterveyttä sekä näkemistä Suomussalmella Kello-Optiikka Lappalaisella
Näöntutkimuksessa kannattaa käydä säännöllisesti noin 2-3 vuoden välein, tai viimeistään siinä vaiheessa, kun huomaa näkemisessä uusia ongelmia. Optometristit (optikot) ja silmätautienerikoislääkärit (silmälääkärit) tutkivat näöntutkimuksen yhteydessä myös silmäterveyttä. Optometristi voi tutkia silmänpohjan keskeisen alueen terveyttä myös modernilla OCT-kuvantamismenetelmällä. Mikäli optometristi havaitsee näöntutkimuksen yhteydessä jonkin hoitoa vaativan silmäsairauden, joka ei ole jo hoidon alla, tulee aina käydä myös silmätautienerikoislääkärin tutkimuksessa. Ajanvarauksen näöntutkimukseen voi tehdä myös nettisivulta: www.kello-optiikka.fi/ajanvaraus

Silmänpohjan keskeisiä alueita pystytään tutkimaan tehokkaasti myös OCT-kuvauksella
Kaukonäköongelmat liitetään usein likinäköön eli miinus-taittoisuuteen sekä hajataittoisuuteen eli astigmatismiin. Kaukonäköongelmia voi kuitenkin olla myös plus-taitteisilla ihmisillä. Näiden ongelmien jo varhainen korjaaminen esimerkiksi silmälaseilla tai piilolaseilla vähentävät silmien rasitusta ja parantaa ihmisen näkemisen laatua.
Lähinäköongelmat liitetään yleensä ikääntymiseen, mutta myös nuorilla sekä nuorilla aikuisilla voi olla ongelmia lähelle näkemisessä. Näihin ongelmiin yleensä auttaa, joko erilliset lähilasit tai sitten monitehoiset lasit. Monitehoinen linssi tarkoittaa sitä, että siinä näköalueita liukuvasti venytetään, esimerkiksi kaukonäkemisen ja lähinäkemisen välillä.

Suomalaiset OLO Tarkka moniteholinssit. Moniteholinsseillä näkee liukuvasti kauas, välietäisyydelle sekä lähelle.
Silmänpohjarappeuma
Silmänpohjarappeuma jaetaan yleensä karkeasti kahteen kategoriaan: kuivaan ja kosteaan silmänpohjarappeumaan. Rappeuma kohdistuu yleensä tarkan näkemisen keskuksen (eli makulan) alueelle ja sen ympärille. Kuivasta silmänpohjarappeumasta käytetään myös yleisesti nimeä silmänpohjan/verkkokalvon ikärappeuma.
Kuivassa silmänpohjarappeumassa silmänpohjassa sijaitseva RPE-aistisolukerros, jossa näkemisen kannalta tärkeät tappi- ja sauvasolut sijaitsevat, alkaa rappeutumaan ja menee monesti poimuiseksi, joka hankaloittaa tarkkaa näkemistä. Pitkälle edenneessä kuivassa silmänpohjarappeumassa puolestaan RPE-kerros atrofisoituu, eli surkastuu, keskeiseltä näkökentältä lähes kokonaan, jolloin ihminen ei kykene enää ilman suurentavia apuvälineitä tarkkaan näkemiseen. Yleensä tällainenkaan tilanne ei täysin kokonaan sokeuta, sillä surkastuminen vain hyvin harvoissa tapauksissa yltää ääreisnäkemisen alueelle. Kuivaan silmänpohjarappeumaan ei nykylääketiede tunne tarkkaa syytä ja sitä ei osata parantaa. Terveet elämäntavat, terveellinen ruokavalio ja tietyt mm. luteenipitoiset lisäravinteet auttavat kuitenkin hillitsemään sen etenemistä. Nykyisin tutkitaan myös tiettyjen valohoitomuotojen vaikutusta kuivaan silmänpohjarappeumaan.

Kuiva silmänpohjan ikärappeuma

Atrofisoitunut kuiva silmänpohjarappeuma
Kosteassa silmänpohjarappeumassa puolestaan verkokalvokerrosten alle alkaa kasvamaan hauraita verisuonia, jotka tihkuvat verta ja nesteitä. Kostea silmänpohjarappeuma kehittyy yleensä nopeasti ja aiheuttaa näkökentässä suorien viivojen yht’äkkistä vääristymistä sekä osassa tapauksissa myös keskeisessä näkökentässä läiskämäisiä puutosalueita. Kostea silmänpohjarappeuma vaatii aina silmätautienerikoislääkärin tarkempaa tutkimusta ja hoitoa. Yleisin tähän Suomessa käytetty hoitomuoto on lasiaistilaan annosteltavat verisuonikasvutekijöiden estäjät, jotka vähentävät nestettä tihkuvien uudissuonten muodostumista.
Nestekertymää silmänpohjan verkkokalvokerrosten alla
Glaukooma
Glaukooma tunnetaan vanhalta nimeltään viherkaihina sekä silmänpainetautina. Nämä vanhat nimet antavat kuitenkin täysin väärän kuvan taudista, jolla ei siis ole mitään tekemistä kaihin kanssa ja läheskään jokaisella glaukoomaa sairastavalla silmänpaine ei kohoa keskivertonormaalin yläpuolelle.
Glaukooma on näköhermosairaus, joka lähtee yksinkertaistettuna katkomaan viestiyhteyttä silmänpohjan aistisolujen ja näköaivokuoren väliltä. Mikäli glaukooman hoito laiminlyödään, se johtaa ensin näkökenttäpuutoksiin näkökentän reuna-alueilla ja pitkällä aikavälillä hoitamaton glaukooma sokeuttaa. Glaukooman ensimmäiset merkit havaitaan yleensä silmämikroskoopilla näköhermonpäätä tutkiessa asiaan kouluttautuneen optometristin tai silmätautienerikoislääkärin toimesta. Glaukooma on myös monesti perinnöllinen sairaus. Tämän vuoksi silmien säännöllinen tutkiminen, varsinkin yli 40-vuotiailla on erittäin tärkeää. Silmätautienerikoislääkäri tekee aina lopullisen diagnoosin ja määrittää tarvittavat hoitokeinot.

Glaukoomaa pystytään havaitsemaan esimerkiksi näköhermonpään OCT-kuvauksella
Kuivasilmäisyys
Silmät tuntuvat karhealta, niitä kirvelee tai ne vetistävät. Nämä ovat aina merkkinä siitä, että silmän uloin valoa läpäisevä kerros, eli sarveiskalvo, on ärtynyt. Sarveiskalvo on rakenteeltaan täynnä pientä hermotusta ja sen vuoksi äärimmäisen herkkä ärsykkeille. Mikäli ärtymykselle ei löydetä ulkoista tekijää, kuten roskaa, silmävammaa tai vierasesinettä silmästä, on kyseessä yleensä kuivasilmäisyys. Kuivasilmäisyyteen voi olla monta osatekijää, kuten liian vähäinen kyynelneste tai kyynelnesteen liian vähäinen lipidi, eli rasvapitoisuus. Myös tukossa olevat meibomin rauhasten päät, voivat lisätä kuivasilmäisyyden oireita.
Säännöllisesti käytettynä oikeanlainen silmien kosteustippa helpottaa näitä oireita. Varsinkin talvella ilmankosteuden ollessa alhainen, tulisi kosteustippaa käyttää vähintään 5-6 krt/pvä molempiin silmiin. Esimerkiksi Suomalaiset PIILOSET:n valmistamat BioDrop MD Plus- tai Théa:n valmistamat Thealoz Duo-kosteustipat ovat hyvä apu silmien kuivumisoireisiin. Mikäli kosteustipan säännöllinen käyttö ja meibominrauhasten lämpöhoito eivät oireita helpota, tulee hakeutua joko optometristin tai silmätautienerikoislääkärin tarkempaan tutkimukseen.

Suomalaiset BioDrop MD Plus kosteustipat
Pidäthän huolta silmistäsi ja näkemisestäsi.

